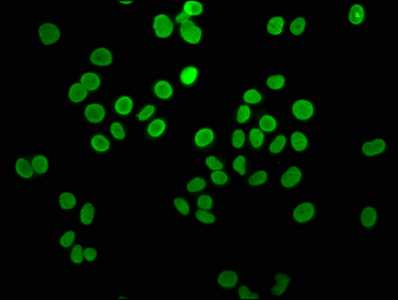

HIST1H4A (Ab-5) Antibody
-
中文名稱:HIST1H4A (Ab-5)兔多克隆抗體
-
貨號:CSB-PA010429OA05ncrHU
-
規格:¥660
-
圖片:
-
Western Blot
Positive WB detected in: Hela whole cell lysate, HepG2 whole cell lysate, A549 whole cell lysate, 293 whole cell lysate, K562 whole cell lysate, Rat spleen tissue
All lanes: HIST1H4A antibody at 0.6μg/ml
Secondary
Goat polyclonal to rabbit IgG at 1/50000 dilution
Predicted band size: 12 kDa
Observed band size: 12 kDa -
IHC image of CSB-PA010429OA05ncrHU diluted at 1:100 and staining in paraffin-embedded human cervical cancer performed on a Leica BondTM system. After dewaxing and hydration, antigen retrieval was mediated by high pressure in a citrate buffer (pH 6.0). Section was blocked with 10% normal goat serum 30min at RT. Then primary antibody (1% BSA) was incubated at 4°C overnight. The primary is detected by a biotinylated secondary antibody and visualized using an HRP conjugated SP system.
-
IHC image of CSB-PA010429OA05ncrHU diluted at 1:100 and staining in paraffin-embedded human small intestine tissue performed on a Leica BondTM system. After dewaxing and hydration, antigen retrieval was mediated by high pressure in a citrate buffer (pH 6.0). Section was blocked with 10% normal goat serum 30min at RT. Then primary antibody (1% BSA) was incubated at 4°C overnight. The primary is detected by a biotinylated secondary antibody and visualized using an HRP conjugated SP system.
-
Immunofluorescence staining of Hela cells with CSB-PA010429OA05ncrHU at 1:5, counter-stained with DAPI. The cells were fixed in 4% formaldehyde, permeabilized using 0.2% Triton X-100 and blocked in 10% normal Goat Serum. The cells were then incubated with the antibody overnight at 4°C. The secondary antibody was Alexa Fluor 488-congugated AffiniPure Goat Anti-Rabbit IgG(H+L).
-
Chromatin Immunoprecipitation Hela (4*106) were treated with Micrococcal Nuclease, sonicated, and immunoprecipitated with 5µg anti-HIST1H4A (CSB-PA010429OA05ncrHU) or a control normal rabbit IgG. The resulting ChIP DNA was quantified using real-time PCR with primers against the β-Globin promoter.
-
Immunoprecipitating HIST1H4A in Hela whole cell lysate
Lane 1: Rabbit control IgG instead of CSB-PA010429OA05ncrHU in Hela whole cell lysate. For western blotting, a HRP-conjugated Protein G antibody was used as the secondary antibody (1/2000)
Lane 2: CSB-PA010429OA05ncrHU (5μg) + Hela whole cell lysate (500μg)
Lane 3: Hela whole cell lysate (20μg)
-
-
其他:
產品詳情
-
產品名稱:Rabbit anti-Homo sapiens (Human) HIST1H4A Polyclonal antibody
-
Uniprot No.:
-
基因名:HIST1H4A
-
別名:dJ160A22.1 antibody; dJ160A22.2 antibody; dJ221C16.1 antibody; dJ221C16.9 antibody; FO108 antibody; H4 antibody; H4.k antibody; H4/a antibody; H4/b antibody; H4/c antibody; H4/d antibody; H4/e antibody; H4/g antibody; H4/h antibody; H4/I antibody; H4/j antibody; H4/k antibody; H4/m antibody; H4/n antibody; H4/p antibody; H4_HUMAN antibody; H4F2 antibody; H4F2iii antibody; H4F2iv antibody; H4FA antibody; H4FB antibody; H4FC antibody; H4FD antibody; H4FE antibody; H4FG antibody; H4FH antibody; H4FI antibody; H4FJ antibody; H4FK antibody; H4FM antibody; H4FN antibody; H4M antibody; HIST1H4A antibody; HIST1H4B antibody; HIST1H4C antibody; HIST1H4D antibody; HIST1H4E antibody; HIST1H4F antibody; HIST1H4H antibody; HIST1H4I antibody; HIST1H4J antibody; HIST1H4K antibody; HIST1H4L antibody; HIST2H4 antibody; HIST2H4A antibody; Hist4h4 antibody; Histone 1 H4a antibody; Histone 1 H4b antibody; Histone 1 H4c antibody; Histone 1 H4d antibody; Histone 1 H4e antibody; Histone 1 H4f antibody; Histone 1 H4h antibody; Histone 1 H4i antibody; Histone 1 H4j antibody; Histone 1 H4k antibody; Histone 1 H4l antibody; Histone 2 H4a antibody; histone 4 H4 antibody; Histone H4 antibody; MGC24116 antibody
-
宿主:Rabbit
-
反應種屬:Human, Rat
-
免疫原:Peptide sequence around site of Lys (5) derived from Human Histone H4
-
免疫原種屬:Homo sapiens (Human)
-
標記方式:Non-conjugated
-
克隆類型:Polyclonal
-
抗體亞型:IgG
-
純化方式:Antigen Affinity Purified
-
濃度:It differs from different batches. Please contact us to confirm it.
-
保存緩沖液:Preservative: 0.03% Proclin 300
Constituents: 50% Glycerol, 0.01M PBS, pH 7.4 -
產品提供形式:Liquid
-
應用范圍:ELISA, WB, IHC, IF, IP, ChIP
-
推薦稀釋比:
Application Recommended Dilution WB 1:100-1:1000 IHC 1:20-1:200 IF 1:1-1:10 IP 1:200-1:2000 -
Protocols:
-
儲存條件:Upon receipt, store at -20°C or -80°C. Avoid repeated freeze.
-
貨期:Basically, we can dispatch the products out in 1-3 working days after receiving your orders. Delivery time maybe differs from different purchasing way or location, please kindly consult your local distributors for specific delivery time.
-
用途:For Research Use Only. Not for use in diagnostic or therapeutic procedures.
相關產品
靶點詳情
-
功能:Core component of nucleosome. Nucleosomes wrap and compact DNA into chromatin, limiting DNA accessibility to the cellular machineries which require DNA as a template. Histones thereby play a central role in transcription regulation, DNA repair, DNA replication and chromosomal stability. DNA accessibility is regulated via a complex set of post-translational modifications of histones, also called histone code, and nucleosome remodeling.
-
基因功能參考文獻:
- ata show that PP32 and SET/TAF-Ibeta proteins block HAT1-mediated H4 acetylation. PMID: 28977641
- Data suggest post-translational modifications of histones, trimethylation of lysine 36 in H3 (H3K36me3) and acetylation of lysine 16 in H4 (H4K16ac), have roles in DNA damage repair; H3K36me3 stimulates H4K16ac upon DNA double-strand break; SETD2, LEDGF, and KAT5 are required for these epigenetic changes. (SETD2 = SET domain containing 2; LEDGF = lens epithelium-derived growth factor; KAT5 = lysine acetyltransferase 5) PMID: 28546430
- Data show that Omomyc protein co-localized with proto-oncogene protein c-myc (c-Myc), protein arginine methyltransferase 5 (PRMT5) and histone H4 H4R3me2s-enriched chromatin domains. PMID: 26563484
- H4K12ac is regulated by estrogen receptor-alpha and is associated with BRD4 function and inducible transcription PMID: 25788266
- Systemic lupus erythematosus appears to be associated with an imbalance in histone acetyltransferases and histone deacetylase enzymes favoring pathologic H4 acetylation. PMID: 25611806
- Sumoylated human histone H4 prevents chromatin compaction by inhibiting long-range internucleosomal interactions. PMID: 25294883
- Acetylation at lysine 5 of histone H4 associated with lytic gene promoters during reactivation of Kaposi's sarcoma-associated herpesvirus. PMID: 25283865
- An increase in histone H4 acetylation caused by hypoxia in human neuroblastoma cell lines corresponds to increased levels of N-myc transcription factor in these cells. PMID: 24481548
- Data indicate that G1-phase histone assembly is restricted to CENP-A and H4. PMID: 23363600
- This study focused on the distribution of a specific histone modification, namely H4K12ac, in human sperm and characterized its specific enrichment sites in promoters throughout the whole human genome. PMID: 22894908
- SRP68/72 heterodimers as major nuclear proteins whose binding of histone H4 tail is inhibited by H4R3 methylation. PMID: 23048028
- TNF-alpha inhibition of AQP5 expression in human salivary gland acinar cells is due to the epigenetic mechanism by suppression of acetylation of histone H4. PMID: 21973049
- our data suggest that global histone H3 and H4 modification patterns are potential markers of tumor recurrence and disease-free survival in non-small cell lung cancer PMID: 22360506
- HAT1 differentially impacts nucleosome assembly of H3.1-H4 and H3.3-H4. PMID: 22228774
- phosphorylation of histone H4 Ser 47 catalyzed by the PAK2 kinase, promotes nucleosome assembly of H3.3-H4 and inhibits nucleosome assembly of H3.1-H4 by increasing the binding affinity of HIRA to H3.3-H4 and reducing association of CAF-1 with H3.1-H4 PMID: 21724829
- the imatinib-induced hemoglobinization and erythroid differentiation in K562 cells are associated with global histone H4 PMID: 20949922
- Our findings reveal the molecular mechanisms whereby the DNA sequences within specific gene bodies are sufficient to nucleate the monomethylation of histone H4 lysine 200 which, in turn, reduces gene expression by half. PMID: 20512922
- Downregulated by zinc and upregulated by docosahexaenoate in a neuroblastoma cell line. PMID: 19747413
- low levels of histone acetylation is associated with the development and progression of gastric carcinomas, possibly through alteration of gene expression PMID: 12385581
- overexpression of MTA1 protein and acetylation level of histone H4 protein are closely related PMID: 15095300
- peptidylarginine deiminase 4 regulates histone Arg methylation by converting methyl-Arg to citrulline and releasing methylamine; data suggest that PAD4 mediates gene expression by regulating Arg methylation and citrullination in histones PMID: 15345777
- lack of biotinylation of K12 in histone H4 is an early signaling event in response to double-strand breaks PMID: 16177192
- incorporation of acetylated histone H4-K16 into nucleosomal arrays inhibits the formation of compact 30-nanometer-like fibers and impedes the ability of chromatin to form cross-fiber interactions PMID: 16469925
- Apoptosis is associated with global DNA hypomethylation and histone deacetylation events in leukemia cells. PMID: 16531610
- BTG2 contributes to retinoic acid activity by favoring differentiation through a gene-specific modification of histone H4 arginine methylation and acetylation levels. PMID: 16782888
- Relationship between histone H4 modification, epigenetic regulation of BDNF gene expression, and long-term memory for extinction of conditioned fear. PMID: 17522015
- H4 tail and its acetylation have novel roles in mediating recruitment of multiple regulatory factors that can change chromatin states for transcription regulation PMID: 17548343
- Brd2 bromodomain 2 is monomeric in solution and dynamically interacts with H4-AcK12; additional secondary elements in the long ZA loop may be a common characteristic of BET bromodomains. PMID: 17848202
- Spermatids Hypac-H4 impairment in mixed atrophy did not deteriorate further by AZFc region deletion. PMID: 18001726
- the SET8 and PCNA interaction couples H4-K20 methylation with DNA replication PMID: 18319261
- H4K20 monomethylation and PR-SET7 are important for L3MBTL1 function PMID: 18408754
- High expression of acetylated H4 is more common in aggressive than indolent cutaneous T-cell lymphoma. PMID: 18671804
- Our findings indicate an important role of histone H4 modifications in bronchial carcinogenesis PMID: 18974389
- results indicate, by acetylation of histone H4 K16 during S-phase, early replicating chromatin domains acquire the H4K16ac-K20me2 epigenetic label that persists on the chromatin throughout mitosis & is deacetylated in early G1-phase of the next cell cycle PMID: 19348949
- acetylated H4 is overexpressed in diffuse large B-cell lymphoma and peripheral T-cell lymphoma relative to normal lymphoid tissue. PMID: 19438744
- The release of histone H4 by holocrine secretion from the sebaceous gland may play an important role in innate immunity. PMID: 19536143
- histone modification including PRC2-mediated repressive histone marker H3K27me3 and active histone marker acH4 may involve in CD11b transcription during HL-60 leukemia cells reprogramming to terminal differentiation PMID: 19578722
- A role of Cdk7 in regulating elongation is further suggested by enhanced histone H4 acetylation and diminished histone H4 trimethylation on lysine 36-two marks of elongation-within genes when the kinase was inhibited. PMID: 19667075
- Data showed the dynamic fluctuation of histone H4 acetylation levels during mitosis, as well as acetylation changes in response to structurally distinct histone deacetylase inhibitors. PMID: 19805290
- Data directly implicate BBAP in the monoubiquitylation and additional posttranslational modification of histone H4 and an associated DNA damage response. PMID: 19818714
顯示更多
收起更多
-
相關疾病:Chromosomal aberrations involving HISTONE H4 is a cause of B-cell non-Hodgkin lymphomas (B-cell NHL). Translocation t(3;6)(q27;p21), with BCL6.
-
亞細胞定位:Nucleus. Chromosome.
-
蛋白家族:Histone H4 family
-
數據庫鏈接:
Most popular with customers
-
-
YWHAB Recombinant Monoclonal Antibody
Applications: ELISA, WB, IHC, IF, FC
Species Reactivity: Human, Mouse, Rat
-
Phospho-YAP1 (S127) Recombinant Monoclonal Antibody
Applications: ELISA, WB, IHC
Species Reactivity: Human
-
-
-
-
-